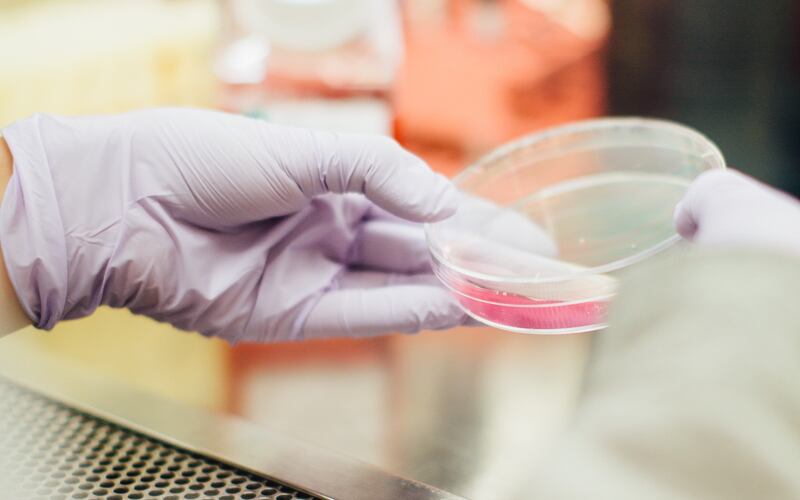

A doença de Alzheimer é uma condição devastadora que afeta milhões de pessoas em todo o mundo. Recentemente, uma pesquisa liderada pela professora Yvonne Nolan, do Centro de Pesquisa APC Microbiome Ireland, fez uma descoberta notável que pode revolucionar a compreensão da doença e suas possíveis abordagens de tratamento.
De acordo com o Mega Curioso, o estudo, que envolveu 69 pacientes diagnosticados com Alzheimer e 64 indivíduos saudáveis, concentrou-se na relação entre o microbioma intestinal e a doença de Alzheimer. Amostras de sangue e fezes foram coletadas de ambos os grupos e submetidas a um procedimento inovador: o transplante de microbiota fecal (FMT).

Os resultados foram surpreendentes. Os pacientes com Alzheimer apresentaram níveis mais elevados de bactérias associadas à inflamação em suas amostras fecais, e esses níveis de bactérias inflamatórias estavam diretamente ligados ao grau de comprometimento cognitivo nos pacientes.
Para aprofundar a investigação, os pesquisadores realizaram o transplante de micróbios intestinais dos pacientes com a doença em ratos saudáveis após eliminar a microbiota natural dos roedores com antibióticos. O resultado foi impressionante: os ratos desenvolveram sintomas associados à demência, indicando a influência do microbioma intestinal na doença de Alzheimer.
Uma das descobertas mais intrigantes foi a observação da neurogênese do hipocampo, o processo de criação de novos neurônios no cérebro. Testes de memória revelaram que os ratos com bactérias intestinais de pacientes com Alzheimer produziram menos células nervosas novas, o que resultou em prejuízos significativos na memória.
Essa pesquisa levanta questões importantes sobre o papel do intestino na doença de Alzheimer e poderia abrir novos caminhos para o tratamento e prevenção da doença. Embora haja muito a ser explorado nessa área, essa descoberta é um marco significativo na busca por soluções para uma das doenças neurodegenerativas mais desafiadoras da atualidade.

